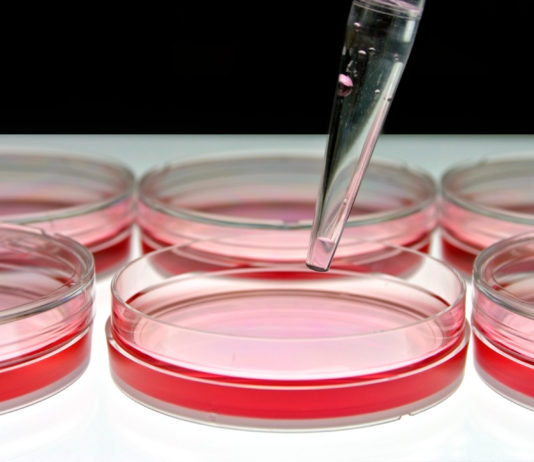
Report ALTEX 2026

IPAM – Piattaforma italiana per i metodi alternativi, nasce l’8 maggio 2003 da quattordici soci fondatori appartenenti a quattro aeree di interesse
- Istituzioni Governative
- Industria
- Mondo Scientifico
- Organizzazioni animaliste e per il benessere animale
con l’obiettivo di promuovere e diffondere la cultura delle 3R, nei suoi aspetti teorico-applicativi, nella sperimentazione scientifica e in ambito regolatorio.